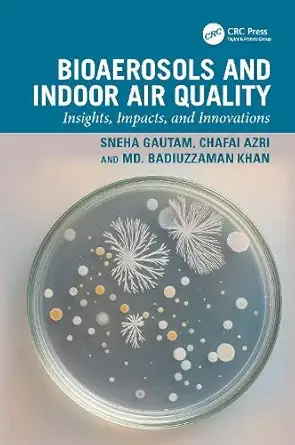
bioaerosols and indoor air quality insights impacts and innovations 1st edition sneha gautam ,chafai azri ,md

Shell Structures For Architecture Form Finding And Optimization(1st Edition)
Authors:
Sigrid Adriaenssens ,Philippe Block ,Diederik Veenendaal ,Chris Williams
Type:Hardcover/ PaperBack / Loose Leaf
Condition: Used/New
In Stock: 1 Left
Shipment time
Expected shipping within 2 - 3 DaysPopular items with books
Access to 35 Million+ Textbooks solutions
Free ✝
Ask Unlimited Questions from expert
AI-Powered Answers
30 Min Free Tutoring Session
✝ 7 days-trial
Total Price:
$117.6
List Price: $168.00
Savings: $50.4
(30%)
Solution Manual Includes
Access to 30 Million+ solutions
Ask 50 Questions from expert
AI-Powered Answers
24/7 Tutor Help
Detailed solutions for Shell Structures For Architecture Form Finding And Optimization
Price:
$9.99
/month
Book details
ISBN: 0415840600, 978-0415840606
Book publisher: Routledge
Offer Just for You!:
Buy 2 books before the end of January and enter our lucky draw.
Customers also bought these books (16)
Popular Among Students (13)
Customer Reviews
Trusted feedback from verified buyers
BH
Delivery was considerably fast, and the book I received was in a good condition.